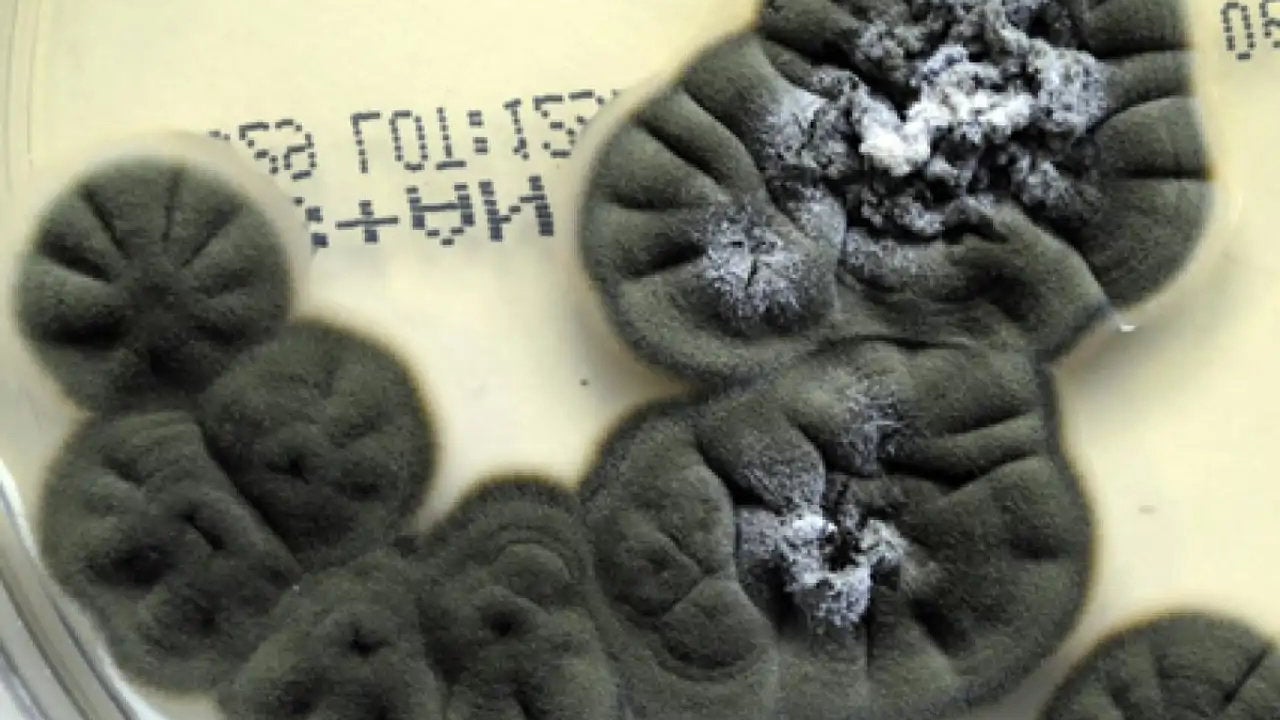
Cultivo del hongo Cladosporium sphaerospermum

Ciencia
Para nosotros, la zona de exclusión de Chernóbil es un territorio prohibido. Bueno, aquí hay que hacer un inciso, ya que hay algunas partes que sí se pueden visitar con un guía. Dicho esto, para otras formas de vida, es todo lo contrario: un hogar. Han pasado cuatro décadas desde la explosión del reactor nuclear número cuatro y, contra todo pronóstico, la vida se ha abierto paso. Es cierto que la falta de humanos merodeando por allí tiene mucho que ver. Sin embargo, hay un organismo en concreto que no solo sobrevive, sino que parece haber convertido la radiación ionizante en su mayor ventana evolutiva.
Hablamos de un extraño hongo negro. Está literalmente aferrado a las paredes de uno de los edificios más radiactivos del planeta y, sorprendentemente, está viviendo su mejor vida. Esta historia empezó en los años 90, cuando un equipo liderado por la microbióloga ucraniana Nelli Zhdanova se aventuró en las ruinas del reactor para ver si algo había logrado sobrevivir bajo aquel inmenso sarcófago. Lo que encontraron los dejó de piedra: había una gran variedad de hongos. Documentaros hasta 37 especies distintas, casi todas en tonos oscuros y repletas de melanina. Pero había uno que destacaba sobre el resto, un hongo llamado Cladosporium sphaerospermum, que acumulaba los niveles más altos de radiactividad.
Unos años más tarde, la radiofarmacóloga Ekaterina Dadachova y el inmunólogo Arturo Casadevall decidieron investigar un poco más. Se dieron cuenta de que bañar a este hongo en radiación ionizante no le hacía nada. No solo la soportaba como si nada, sino que crecía más rápido. Ante esto, los científicos lanzaron una teoría espectacular conocida como radiosíntesis. Por lo visto, el hongo usa la melanina igual que las plantas usan la clorofila. Absorbe la radiación, se protege de ella y, de paso, la transforma en energía.
Unos años más tarde, en 2022, a alguien se le ocurrió la idea de llevarse el hongo al espacio. Lo pegaron en el exterior de la Estación Espacial Internacional, dejándolo a merced de la radiación cósmica. ¿El resultado? Los sensores demostraron que la capa del hongo bloqueaba parte de la radiación. A pesar de lo increíble que suena todo esto, hay un pequeño problema: en realidad, todavía no sabemos exactamente cómo lo hace. Científicos como Nils Averesch, recuerdan que la radiosíntesis sigue siendo una hipótesis difícil de probar.